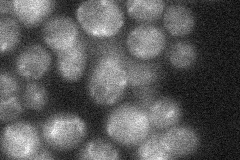
YJL059W
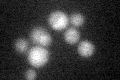
YJL059W

View description
Vacuolar membrane protein involved in the ATP-dependent transport of arginine into the vacuole and possibly in balancing ion homeostasis; homolog of human CLN3 involved in Batten disease (juvenile onset neuronal ceroid lipofuscinosis)
Localization:
Intensity:
Fold change:
Significance:
-
C’ GFP library in SD

below threshold15.14 -
N' NOP1pr-GFP in SD

punctate66.8798 -
N' TEF2pr-mCherry in SD

punctate,vacuole97.4776 -
N' NATIVEpr-GFP in SD
ambiguous21.198 -
N' TEF2pr-VC and Cyto-VN in SD

punctate29.6768 -
C’ GFP library in SD+DTT
cytosol14.650.96No -
C’ GFP library in SD+H2O2

cytosol13.930.91No -
C’ GFP library in Starvation Media

cytosol15.211No -
C’ GFP library on the background of Pup2-DaMP

N/A -
C’ GFP library on the background of CCT mutant

N/A0N/AYes
